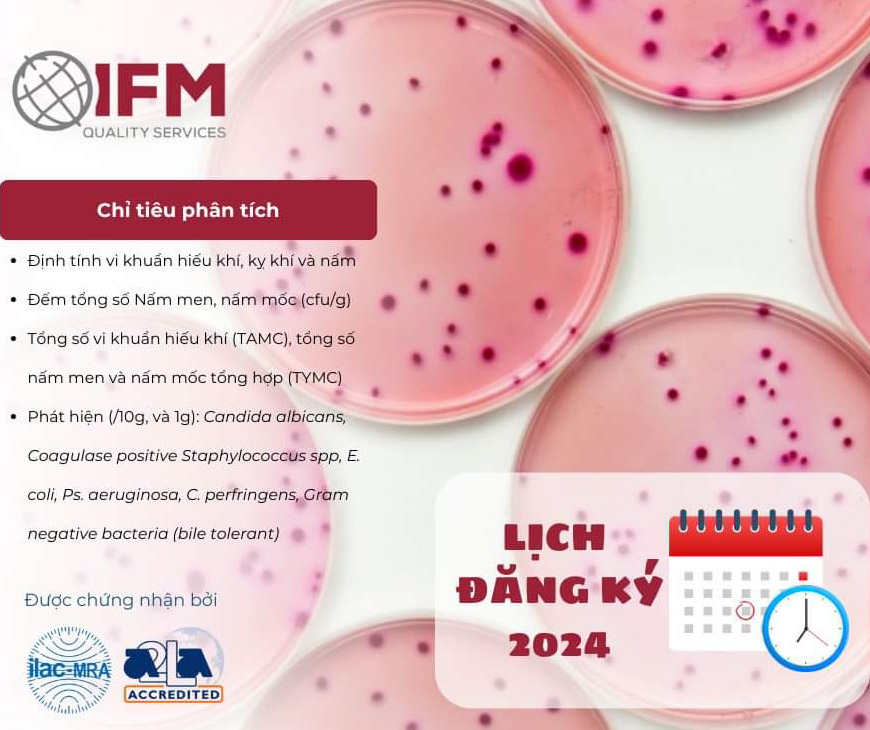

Xin kính chào Quý khách hàng và bạn bè yêu khoa học tại Việt Nam!
Hello customers and friends who love science in Vietnam!
Chúng tôi rất phấn khởi khi giới thiệu đến bạn về Công ty IFM Quality Service – Đối tác đáng tin cậy trong lĩnh vực Chương Trình Thử Nghiệm Thành Thạo (PT)!
We are very excited to introduce to you IFM Quality Service Company – a reliable partner in the field of Proficiency Testing (PT) Programs!
Hello customers and friends who love science in Vietnam!
Chúng tôi rất phấn khởi khi giới thiệu đến bạn về Công ty IFM Quality Service – Đối tác đáng tin cậy trong lĩnh vực Chương Trình Thử Nghiệm Thành Thạo (PT)!
We are very excited to introduce to you IFM Quality Service Company – a reliable partner in the field of Proficiency Testing (PT) Programs!
Chương Trình Thử Nghiệm Thành Thạo (PT – Life Science Proficiency Testing):
IFM Quality Service cung cấp chương trình PT để đánh giá và nâng cao khả năng tay nghề của đội ngũ nghiên cứu và phòng thí nghiệm của bạn. Chúng tôi đảm bảo bạn luôn đạt được sự chính xác và đáng tin cậy trong mọi thử nghiệm và nghiên cứu, giúp bạn luôn tự tin với kết quả trong lĩnh vực Khoa Học Sự Sống.
Life Science Proficiency Testing (PT – PT) Program:
IFM Quality Service offers a PT program to assess and enhance the technical capabilities of your research and laboratory staff. We ensure you always achieve accuracy and reliability in every test and research, giving you confidence in your results in the field of Life Sciences.
IFM Quality Service tại Việt Nam:
Chúng tôi, Công Ty TNHH Khoa Học Kỹ Thuật Toàn Cầu, là nhà phân phối chính hãng của IFM tại Việt Nam. Với cam kết về chất lượng và sự phục vụ tận tâm, chúng tôi luôn sẵn sàng hỗ trợ bạn trong mọi dự án và nghiên cứu.
IFM Quality Service in Vietnam:
We, Global Science and Technology Company Limited, are the official distributor of IFM in Vietnam. With a commitment to quality and dedicated service, we are always ready to support you in every project and research.
Hãy liên hệ với chúng tôi để biết thêm về các sản phẩm và dịch vụ của IFM Quality Service. Chúng tôi đang chờ đợi cơ hội hợp tác cùng bạn và mang đến giải pháp khoa học và công nghệ tốt nhất.
Please contact us to know more about IFM Quality Service products and services. We are waiting for the opportunity to cooperate with you and bring the best scientific and technological solutions.
Hãy liên hệ với chúng tôi để biết thêm về các sản phẩm và dịch vụ của IFM Quality Service. Chúng tôi đang chờ đợi cơ hội hợp tác cùng bạn và mang đến giải pháp khoa học và công nghệ tốt nhất.
Please contact us to know more about IFM Quality Service products and services. We are waiting for the opportunity to cooperate with you and bring the best scientific and technological solutions.

Đánh giá
Chưa có đánh giá nào.